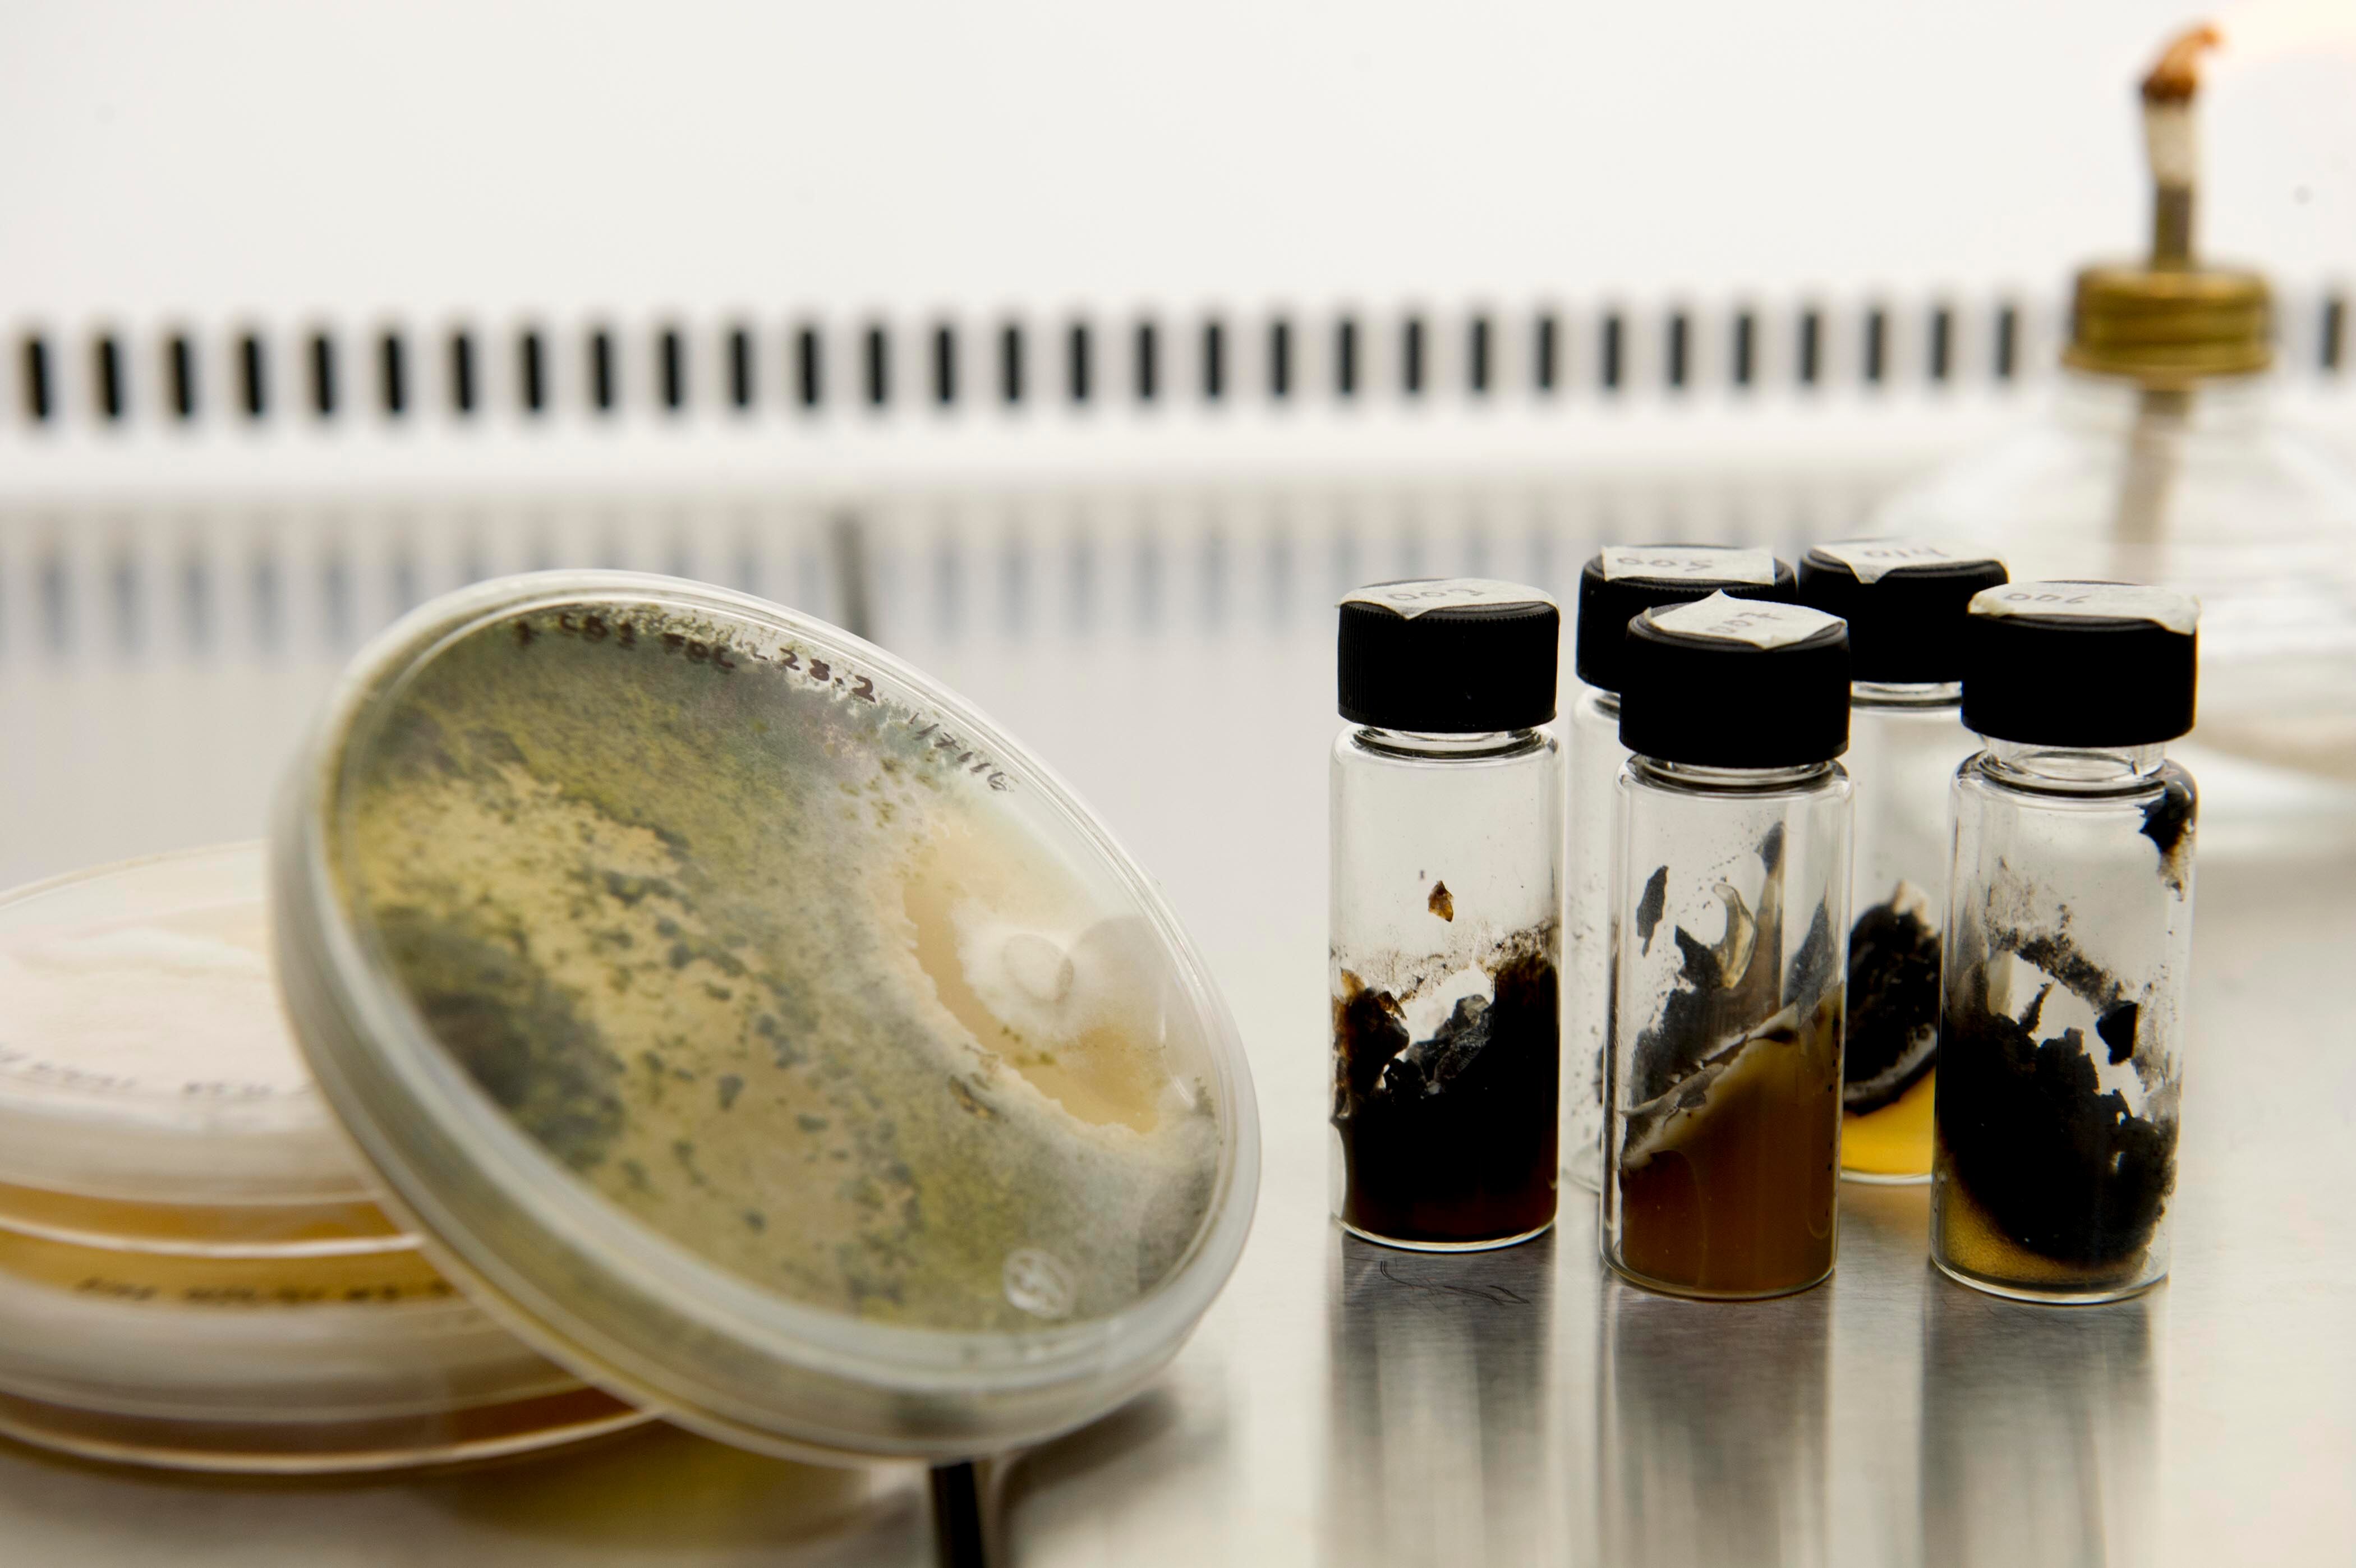

Su pasión la lleva incluso en sus accesorios: en sus orejas destacaban aretes en forma de hongos, los organismos que han moldeado su vida profesional desde que tiene 20 años.
Este miércoles la micóloga –especialista en el estudio de hongos– Priscila Chaverri recibió el premio a la Científica Destacada del Año, galardón otorgado por el Ministerio de Ciencia y Tecnología y la Academia Nacional de Ciencias para honrar el papel de la mujer costarricense en el quehacer científico.
Ella enfocó sus estudios en los hongos, especialmente de un orden llamado Hypocrea, y, dentro de ellos, un género llamado Trichoderma.
Estos organismos pueden enfermar a las plantas, o, por el contrario, servir de control biológico para matar insectos dañinos y controlar plagas.
“Desde un inicio me interesaron estos hongos porque es una forma natural de prevenir enfermedades de las plantas y cultivos. Soy patóloga vegetal. Es como ser una doctora de plantas”, expresó a La Nación.
Luchadora. Para llegar donde hoy está, esta oriunda de San Pedro de Montes de Oca invirtió varios años de estudio, hizo gran cantidad de giras de campo e investigaciones.

Además, aprendió a distribuir su tiempo entre el trabajo y su hijo. No obstante, su mayor reto fue hace cuatro años cuando le correspondió enfrentarse a un cáncer de mama y vencerlo.
Chaverri recuerda que su primer contacto con los hongos los tuvo lugar cuando estudió Ingeniería Forestal en el Instituto Tecnológico de Costa Rica (ITCR), sitio donde recibió este miércoles su reconocimiento.
“Ahí fue donde me empezó a interesar la protección forestal, las plagas y las enfermedades de las árboles. Estuve trabajando con una profesora, con Marcela Piedra. Me gustó tanto lo que ella hacía que me ofrecí de voluntaria”, rememora.
Luego de graduarse, comenzó a trabajar en el Instituto Nacional de Biodiversidad (InBio). Ahí creció la pasión por los hongos.
Su trabajo en el instituto consistía en buscar dichos organismo, para luego hacerles la taxonomía: poner sus características completas y ver para qué podían ser útiles. Esas pesquisas se llevaron a cabo en el Parque Nacional Santa Rosa, en Guanacaste.
A los dos años tomó la decisión de hacer un doctorado en la Universidad de Pennsylvania en Estados Unidos. Su labor durante un lustro fue caracterizar los hongos Trychoderma.
“Hay 300 especies de Trichoderma; en Costa Rica pueden haber 150. Crecen dentro de los tejidos vivos de las plantas o en el suelo. Por mis investigaciones, me he dado cuenta que casi todos los árboles tropicales tienen Trichoderma. ¿Por qué la poseen? ¿para qué les sirven? Eso fue lo que me dispuse a averiguar”, manifestó.
Luego estudió otro género de hongo, también del orden de Hypocrea llamado Hypocreales.
Hace tres años Chaverri regresó a Costa Rica y se alió con CoopeTarrazú para buscar soluciones a los problemas de las plantaciones de café (como la roya y otros), a través de la acción de hongos.
“El control biológico a veces se hace mal. Hay gente que nada más agarra una Trichoderma sin conocer sus características o saber si sirve para determinada plaga o enfermedad. Lo que yo hago diferente es buscar biocontroladores específicos. Y ahí está el mejor resultado” concluyó.
